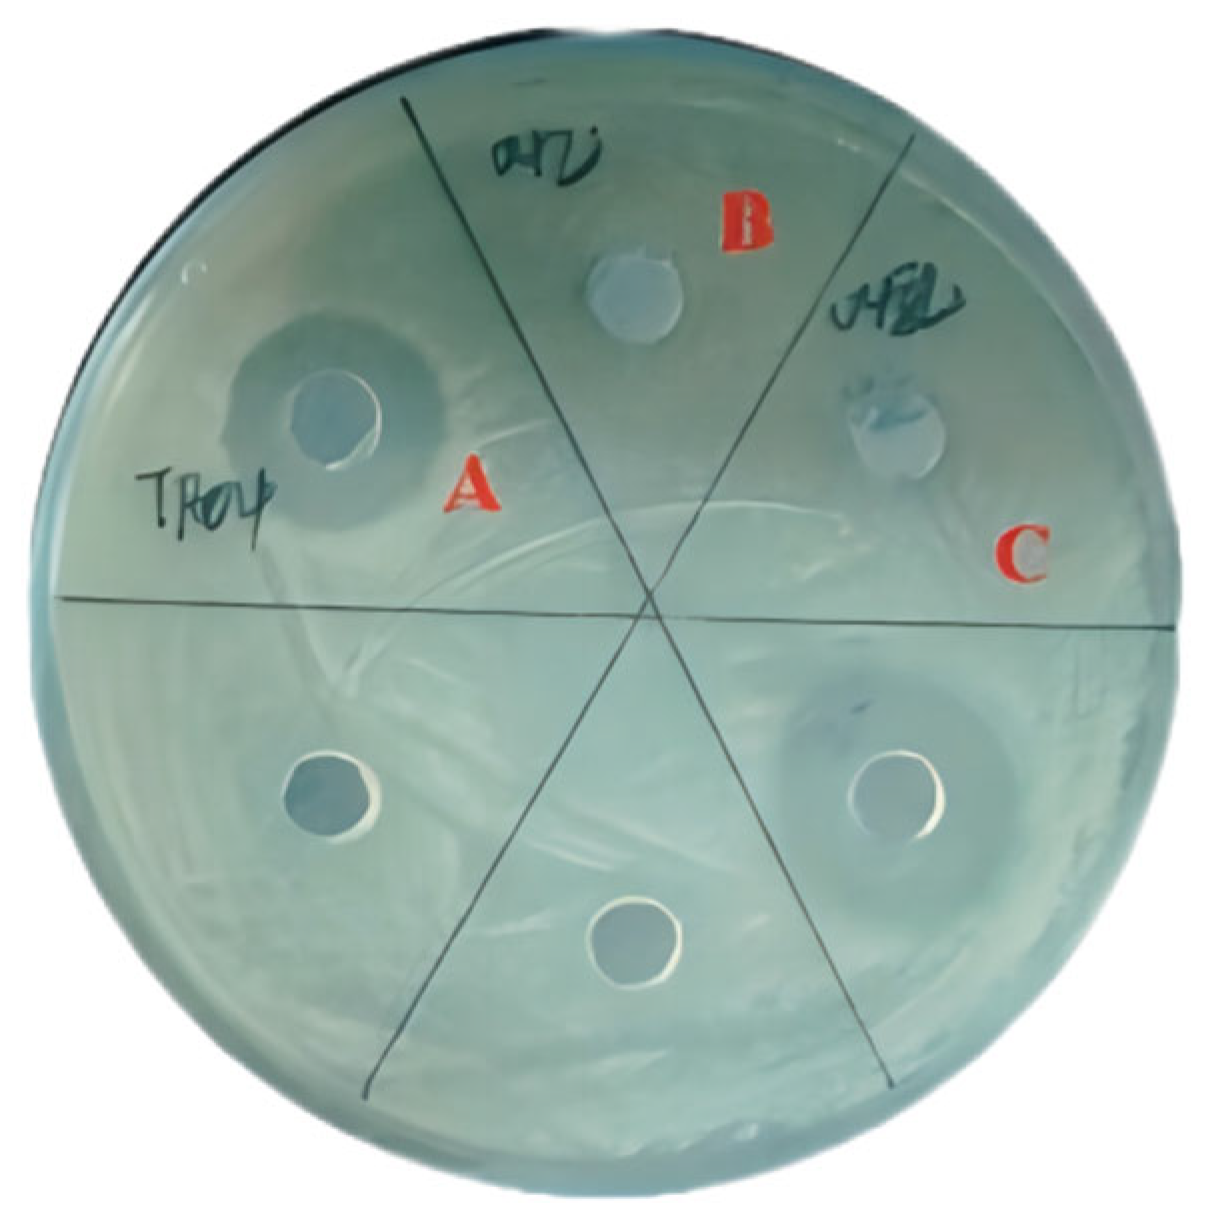

A Bifidobacterium Strain with Antibacterial Activity, Its Antibacterial Characteristics and In Vitro Probiotics Studies
Abstract
1. Introduction
2. Materials and Methods
2.1. Screening of Probiotics with Bacteriostatic Activity
2.2. Strain Identification
2.3. Determination of Strain Growth Curves
2.4. Experiment on the Exclusion of Organic Acids
2.5. Experiment on the Exclusion of Hydrogen Peroxide
2.6. Determination of Protease Sensitivity
2.7. Stability Test of Bacteriostatic Agent
2.7.1. Determination of Acid-Base Stability
2.7.2. Determination of Thermal Stability
2.7.3. Determination of Ultraviolet Stability
2.8. Probiotic Analysis
2.8.1. Resistance to Low pH
2.8.2. Resistance to Bile Salts
2.8.3. Auto-Aggregation Ability and Hydrophobicity
2.8.4. Hemolytic Activity
2.8.5. Gelatinase Activity
2.8.6. DPPH Reduction Activity
2.8.7. Hydroxyl Radical Reduction Activity
2.8.8. Statistical Analysis
3. Results
3.1. Screening of Probiotics with Bacteriostatic Activity
3.2. Strain Identification
3.3. The Growth Curve of Strain TF04
3.4. Preliminary Identification of Antimicrobial Active Substances from Strain TF04
3.4.1. Exclusion of Organic Acids as Primary Antimicrobial Factors
3.4.2. Exclusion of Hydrogen Peroxide
3.4.3. Protease Sensitivity of Bacteriostatic Agent
3.5. Stability Test of Bacteriostatic Agent
3.5.1. Acid-Base Stability of Bacteriostatic Agent
3.5.2. Thermal Stability and Ultraviolet Stability of Bacteriostatic Agent
3.6. Probiotic Analysis
3.6.1. Resistance to Low pH and Bile Salts
3.6.2. Auto-Aggregation Ability and Hydrophobicity
3.6.3. Safety Assessment of Bifidobacterium sp. Strain TF04
3.6.4. Antioxidant Activity of Bifidobacterium sp. Strain TF04
4. Discussion
5. Conclusions
Author Contributions
Funding
Institutional Review Board Statement
Informed Consent Statement
Data Availability Statement
Conflicts of Interest
References
- WHO; FAO. Health and Nutritional Properties of Probiotics in Food Including Powder Milk with Live Lactic Acid Bacteria—Joint FAO/WHO Expert Consultation; WHO/FAO: Geneva, Switzerland, 2001. [Google Scholar]
- Saxelin, M.; Tynkkynen, S.; Mattila-Sandholm, T.; de Vos, W.M. Probiotic and other functional microbes: From markets to mechanisms. Curr. Opin. Biotechnol. 2002, 13, 483–487. [Google Scholar] [CrossRef] [PubMed]
- Hill, C.; Guarner, F.; Reid, G.; Gibson, G.R.; Merenstein, D.J.; Pot, B.; Morelli, L.; Canani, R.B.; Flint, H.J.; Salminen, S.; et al. The International Scientific Association for Probiotics and Prebiotics consensus statement on the scope and appropriate use of the term probiotic. Nat. Rev. Gastroenterol. Hepatol. 2014, 11, 506–514. [Google Scholar] [CrossRef]
- McFarland, L.V. Systematic review and meta-analysis of Saccharomyces boulardii in adult patients. World J. Gastroenterol. 2010, 16, 2202–2222. [Google Scholar] [CrossRef] [PubMed]
- Plovier, H.; Everard, A.; Druart, C.; Depommier, C.; van Hul, M.; Geurts, L.; Chilloux, J.; Ottman, N.; van der Ark, K.C.H.; Aalvink, S.; et al. A purified membrane protein from Akkermansia muciniphila improves metabolic profiles in obese mice. Nat. Med. 2017, 23, 107–113. [Google Scholar] [CrossRef]
- Gao, Y.; Dang, L.; Bie, X.; Lv, F.; Zhao, H.; Lu, Z. Different mutation methods of Lactobacillus acidophilus NX2-6 for improving antifungal activity. Sci. Technol. Food Ind. 2015, 9, 184–187. [Google Scholar] [CrossRef]
- Shan, C.J.; Hu, Y.X.; Xia, X.D.; Liu, X.L.; Li, Y.; Wang, Y.; Zhang, J.H.; Zhou, J.Z. Purification and characterization of the bacteriocin produced by Lactobacillus panis C-M_2. Food Sci. 2017, 38, 20–26. [Google Scholar] [CrossRef]
- Sornplang, P.; Piyadeatsoontorn, S. Probiotic isolates from unconventional sources: A review. J. Anim. Sci. Technol. 2016, 58, 26. [Google Scholar] [CrossRef]
- Bhat, M.I.; Kapila, S.; Kapila, R. Lactobacillus fermentum (MTCC-5898) supplementation renders prophylactic action against Escherichia coli impaired intestinal barrier function through tight junction modulation. LWT 2020, 123, 109118. [Google Scholar] [CrossRef]
- Merghni, A.; Dallel, I.; Noumi, E.; Kadmi, Y.; Hentati, H.; Tobji, S.; Amor, A.B.; Mastouri, M. Antioxidant and antiproliferative potential of biosurfactants isolated from Lactobacillus casei and their anti-biofilm effect in oral Staphylococcus aureus strains. Microb. Pathog. 2017, 104, 84–89. [Google Scholar] [CrossRef]
- Huang, P.; Yuan, S.; Xu, X.; Peng, X. Effects of Bifidobacterium lactis HN019 and Lactobacillus acidophilus NCFM on volatile sulfur compounds produced by oral anaerobes. J. Breath Res. 2022, 17, 016002. [Google Scholar] [CrossRef]
- Cizeikiene, D.; Jagelaviciute, J. Investigation of antibacterial activity and probiotic properties of strains belonging to Lactobacillus and Bifidobacterium genera for their potential application in functional food and feed products. Probiotics Antimicrob. Proteins 2021, 13, 1387–1403. [Google Scholar] [CrossRef] [PubMed]
- Guan, C.; Zhang, W.; Su, J.; Li, F.; Chen, D.; Chen, X.; Huang, Y.; Gu, R.; Zhang, C. Antibacterial and antibiofilm potential of Lacticaseibacillus rhamnosus YT and its cell-surface extract. BMC Microbiol. 2023, 23, 12. [Google Scholar] [CrossRef]
- Muñoz-Tebar, N.; Pérez-Álvarez, J.A.; Fernández-López, J.; Viuda-Martos, M. Chitosan edible films and coatings with added bioactive compounds: Antibacterial and antioxidant properties and their application to food products: A review. Polymers 2023, 15, 396. [Google Scholar] [CrossRef]
- Murugan, A.; Banu, A.T.; Lakshmi, D.S. Edible coatings to enhance shelf life of fruits and vegetables: A mini-review. Curr. Nutr. Food Sci. 2022, 18, 525–538. [Google Scholar] [CrossRef]
- O’Sullivan, L.; Ross, R.P.; Hill, C. Potential of bacteriocin-producing lactic acid bacteria for improvements in food safety and quality. Biochimie 2002, 84, 593–604. [Google Scholar] [CrossRef]
- Lee, E.H.; Khan, I.; Oh, D.H. Evaluation of the efficacy of nisin-loaded chitosan nanoparticles against foodborne pathogens in orange juice. J. Food Sci. Technol. 2018, 55, 1127–1133. [Google Scholar] [CrossRef] [PubMed]
- Veettil, V.N. Optimization of bacteriocin production by Lactobacillus plantarum using Response Surface Methodology. Cell. Mol. Biol. 2022, 68, 105–110. [Google Scholar] [CrossRef]
- Yang, Z.; Nie, X.; Liu, K.L.; Zhang, H.P.; Yao, G.Q. Study on active functional components of two Bifidobacterium strains. J. Chin. Inst. Food Sci. Technol. 2024, 24, 37–47. [Google Scholar]
- Dou, S.; Pan, W.; Pan, X.; Li, Y.; Mao, J.; Cheng, J.; Yan, X.; Wang, T.; Zhou, X.; Zhang, S.Y. The organic acid metabolites of Bifidobacterium longum subsp. iuvenis alleviate ultraviolet irradiation-induced photoaging. Microbiol. Res. 2025, 294, 128100. [Google Scholar]
- Long, S.F.; Xu, Y.T.; Pan, L.; Wang, Q.Q.; Wang, C.L.; Wu, J.Y.; Wu, Y.Y.; Han, Y.M.; Yun, C.H.; Piao, X.S. Mixed organic acids as antibiotic substitutes improve performance, serum immunity, intestinal morphology and microbiota for weaned piglets. Anim. Feed Sci. Technol. 2018, 235, 23–32. [Google Scholar] [CrossRef]
- Kawiecki, K.; Stangierski, J.; Konieczny, P. An analysis of oxidative changes and the fatty acid profile in stored poultry sausages with liquid and microencapsulated fish oil additives. Molecules 2021, 26, 4293. [Google Scholar] [CrossRef]
- Wen, W.; Hu, Y.J.; Cheng, H.Z.; He, J. Research progress on the regulatory effect of organic acids on intestinal flora and their antibacterial mechanism in pigs. China Anim. Husb. Vet. Med. 2023, 50, 3133–3141. [Google Scholar]
- Da Costa, R.J.; Voloski, F.L.S.; Mondadori, R.G.; Duval, E.H.; Fiorentini, A.M. Preservation of meat products with bacteriocins produced by lactic acid bacteria isolated from meat. J. Food Qual. 2019, 1, 4726510. [Google Scholar] [CrossRef]
- Eijsink, V.G.; Axelsson, L.; Diep, D.B.; Håvarstein, L.S.; Holo, H.; Nes, I.F. Production of class II bacteriocins by lactic acid bacteria; an example of biological warfare and communication. Antonie Van Leeuwenhoek 2002, 81, 639–654. [Google Scholar] [CrossRef]
- Liu, G.R.; Ren, G.M.; Zhao, L.; Cheng, L. Antibacterial activity and mechanism of bifidocin A against Listeria monocytogenes. Food Control 2017, 73, 854–861. [Google Scholar] [CrossRef]
- Cheikhyoussef, A.; Cheikhyoussef, N.; Chen, H.; Zhao, J.; Tang, J.; Zhang, H.; Chen, W. Bifidin I-A new bacteriocin produced by Bifidobacterium infantis BCRC 14602:Purification and partial amino acid sequence. Food Control 2010, 21, 746–753. [Google Scholar] [CrossRef]
- Peres, C.M.; Alves, M.; Hernandez-Mendoza, A.; Moreira, L.; Silva, S.; Bronze, M.R.; Vilas-Boas, L.; Peres, C.; Malcata, F.X. Novel isolates of lactobacilli from fermented portuguese olive as potential probiotics. LWT Food Sci. Technol. 2014, 59, 234–246. [Google Scholar] [CrossRef]
- Krasaekoopt, W.; Bhandari, B.; Deeth, H. Evaluation of encapsulation techniques of probiotics for yoghurt. Int. Dairy J. 2003, 13, 3–13. [Google Scholar] [CrossRef]
- Maldonado, N.C.; Deruiz de Ruiz, C.S.; Otero, M.C.; Sesma, F.; Nader-Macías, M.E. Lactic acid bacteria isolated from young calves-characterization and potential as probiotics. Res. Vet. Sci. 2012, 92, 342–349. [Google Scholar] [CrossRef]
- Singh, P.K.; Singh, R.P.; Singh, P.; Singh, R.L. Food Hazards: Food Hazards: Physical, Chemical, and Biological. In Food Safety and Human Health; Academic Press: Cambridge, MA, USA, 2019; pp. 15–65. [Google Scholar] [CrossRef]
- Servin, A.L. Antagonistic activities of lactobacilli and bifidobacteria against microbial pathogens. FEMS Microbiol. Rev. 2004, 28, 405–440. [Google Scholar] [CrossRef]
- Mokoena, M.P. Lactic Acid Bacteria and Their Bacteriocins: Classification, Biosynthesis and Applications against Uropathogens: A Mini-Review. Molecules 2017, 22, 1255. [Google Scholar] [CrossRef] [PubMed]
- Liu, Y.; Li, Z.; Lv, Y.; Dong, B.; Fan, Z. Chlamydomonas reinhardtii-expressed multimer of Bacteriocin LS2 potently inhibits the growth of bacteria. Process. Biochem. 2020, 95, 139–147. [Google Scholar] [CrossRef]
- Gupta, A.; Tiwari, S.K. Plantaricin LD1: A Bacteriocin Produced by Food Isolate of Lactobacillus plantarum LD1. Appl. Biochem. Biotechnol. 2014, 172, 3354–3362. [Google Scholar] [CrossRef]
- Dey, B.C.; Rai, N.; Das, S.; Mandal, S.; Mandal, V. Partial purification, characterization and mode of action of bacteriocins produced by three strains of Pediococcus sp. Food Sci. Technol. 2019, 56, 2594–2604. [Google Scholar] [CrossRef] [PubMed]
- Gough, R.; Gómez-Sala, B.; O’Connor, P.M.; Rea, M.C.; Miao, S.; Hill, C.; Brodkorb, A. A Simple Method for the Purification of Nisin. Probiotics Antimicrob. Proteins 2017, 9, 363–369. [Google Scholar] [CrossRef]
- Lasik-Kurdyś, M.; Sip, A. Evaluation of the antimicrobial activity of bacteriocin-like inhibitory substances of enological importance produced by Oenococcus oeni isolated from wine. Eur. Food Res. Technol. 2018, 245, 375–382. [Google Scholar] [CrossRef]
- Jeronymo-Ceneviva, A.B.; de Paula, A.T.; Silva, L.F.; Todorov, S.D.; Mello Franco, B.D.G.; Penna, A.L.B. Probiotic Properties of Lactic Acid Bacteria Isolated from Water-Buffalo Mozzarella Cheese. Probiotics Antimicrob. Proteins 2014, 6, 141–156. [Google Scholar] [CrossRef] [PubMed]
- Wang, G. Antimicrobial Peptides: Structure, Mechanism and Modification. Curr. Pharm. Des. 2018, 24, 1132–1139. [Google Scholar]
- Halami, P.M.; Ramesh, A.; Chandrashekar, A. Fermenting Cucumber, a Potential Source for the Isolation of Pediocin-Like Bacteriocin Producers. World J. Microbiol. Biotechnol. 2005, 21, 1351–1358. [Google Scholar] [CrossRef]
- Pace, C.N.; Grimsley, G.R.; Scholtz, J.M. Contribution of hydrophobic interactions to protein stability. J. Mol. Biol. 2014, 426, 4129–4140. [Google Scholar] [CrossRef]
- Ansari, A.; Zohra, R.R.; Tarar, O.M.; Qader, S.A.U.; Aman, A. Screening, purification and characterization of thermostable, protease resistant Bacteriocin active against methicillin resistant Staphylococcus aureus (MRSA). BMC Microbiol. 2018, 18, 192. [Google Scholar] [CrossRef] [PubMed]
- Le Han, H.; Pham, P.T.V.; Kim, S.G.; Chan, S.S.; Khoo, K.S.; Chew, K.W.; Show, P.L.; Tran, T.N.T.; Nguyen, H.T.V.; Nguyen, P.T.D. Isolation and Characterization of Antimicrobial Peptides Isolated from Brevibacillus halotolerans 7WMA2 for the Activity Against Multidrug-Resistant Pathogens. Mol. Biotechnol. 2024, 66, 3618–3627. [Google Scholar] [CrossRef] [PubMed]
- Busarcevic, M.; Dalgalarrondo, M. Purification and genetic characterisation of the novel bacteriocin LS2 produced by the human oral strain Lactobacillus salivarius BGHO1. Int. J. Antimicrob. Agents 2012, 40, 127–134. [Google Scholar] [CrossRef] [PubMed]
- Wang, Y.S.; Fang, Z.F.; Zhai, Q.X.; Cui, S.M.; Zhao, J.X.; Zhang, H.; Chen, W.; Liu, W.W. Supernatants of Bifidobacterium longum and Lactobacillus plantarum Strains Exhibited Antioxidative Effects on A7R5 Cells. Microorganisms 2021, 9, 452. [Google Scholar] [CrossRef]
- Wang, H.J.; Tian, X.; Chen, Z.J. Biostability of bacteriocin with antimicrobial activity produced by Lactobacillus plantarum. J. Hainan Norm. Univ. Nat. Sci. Ed. 2022, 35, 282–286. [Google Scholar]
- Chen, W. Lactic Acid Bacteria Bioengineering and Industrial Applications; Springer: Singapore, 2019; pp. 61–92. [Google Scholar] [CrossRef]
- Gautam, N.; Sharma, N. Bacteriocin: Safest approach to preserve food products. Indian J. Microbiol. 2009, 49, 204–211. [Google Scholar] [CrossRef]
- Machado, I.M.; Silva, L.R.; Giaouris, E.; Melo, L.F. Quorum sensing in food spoilage and natural-based strategies for its inhibition. Food Res. Int. 2020, 127, 108754. [Google Scholar] [CrossRef]
- Yuan, L.; Sadiqf, A.; Burmolle, M.; Liu, T.; He, G. Insights into bacterial milk spoilage with particular emphasis on the roles of heat-stable enzymes, biofilms, and quorum sensing. J. Food Prot. 2018, 81, 1651–1660. [Google Scholar] [CrossRef]
- Galié, S.; Garcia, G.C.; Migueleze, M.; Villar, C.J.; Lombó, F. Biofilms in the food industry: Health aspects and control methods. Front. Microbiol. 2018, 9, 898. [Google Scholar] [CrossRef]
- Abushelaibi, A.; Al-Mahadin, S.; El-Tarabily, K.; Shah, N.P.; Ayyash, M. Characterization of potential probiotic lactic acid bacteria isolated from camel milk. LWT-Food Sci. Technol. 2017, 79, 316–325. [Google Scholar] [CrossRef]
- Kim, J.; Muhammad, N.; Jhun, B.H.; Yoo, J.W. Probiotic delivery systems: A brief overview. J. Pharm. Investig. 2016, 46, 377–386. [Google Scholar] [CrossRef]
- Song, M.; Yun, B.; Moon, J.H.; Park, D.J.; Lim, K.; Oh, S. Characterization of selected Lactobacillus strains for use as probiotics. Korean J. Food Sci. Anim. Resour. 2015, 35, 551–556. [Google Scholar] [CrossRef] [PubMed]
- Sanz, Y. Ecological and functional implications of the acid-adaptation ability of Bifidobacterium: A way of selecting improved probiotic strains. Int. Dairy J. 2007, 17, 1284–1289. [Google Scholar] [CrossRef]
- Lee, Y.K.; Salminen, S. The coming of age of probiotics. Trends Food Sci. Technol. 1995, 6, 241–245. [Google Scholar] [CrossRef]
- Leccierois, L.; Merieau, A. Bacterial hydrophobicity: An overview from physicochemical to genetic approaches. Microbiology 2020, 166, 890–899. [Google Scholar] [CrossRef]
- Tusonh, H.; Weibel, D.B. Bacteria-surface interactions. Soft Matter 2013, 9, 4368–4380. [Google Scholar] [CrossRef]
- Kline, K.A.; Dodson, K.W.; Caparon, M.G.; Hultgren, S. A tale of two pili: Assembly and function of pili in bacteria. Trends Microbiol. 2010, 18, 224–232. [Google Scholar] [CrossRef]
- Del Re, B.; Gorbati, B.; Miglioli, M.; Palenzona, D. Adhesion, autoaggregation and hydrophobicity of 13 strains of Bifidobacterium longum. J. Appl. Microbiol. 2000, 88, 836–843. [Google Scholar] [CrossRef]
- Shekh, S.L.; Dave, J.M.; Vyas, B.R.M. Characterization of Lactobacillus plantarum strains for functionality, safety and γ-amino butyric acid production. LWT Food Sci. Technol. 2016, 74, 234–241. [Google Scholar] [CrossRef]
- Zhao, L.; Wang, S.; Dong, J.; Shi, J.; Guan, J.; Liu, D.; Liu, F.; Li, B.; Huo, G. Identification, Characterization, and Antioxidant Potential of Bifidobacterium longum subsp. longum Strains Isolated From Feces of Healthy Infants. Front. Microbiol. 2021, 12, 756519. [Google Scholar]
- Yolmeh, M.; Alves, P.C.M.; Vilela, M.M.D.S.; Sant’Ana, A.S. Impacts of ohmic-heating on the surface characteristics, membrane integrity, morphology, and chemical compounds of Bifidobacterium animalis paraprobiotic. Food Biosci. 2024, 59, 104141. [Google Scholar] [CrossRef]
- Khagwal, N.; Sharma, P.K.; Sharma, D.C. Screening and evaluation of Lactobacillus spp. for the development of potential probiotics. Afr. J. Microbiol. Res. 2014, 15, 1573–1579. [Google Scholar]
- Fonseca, H.C.; de Sousa Melo, D.; Ramos, C.L.; Dias, D.R.; Schwan, R.F. Probiotic Properties of Lactobacilli and Their Ability to Inhibit the Adhesion of Enteropathogenic Bacteria to Caco-2 and HT-29 Cells. Probiotics Antimicrob. Proteins 2021, 13, 102–112. [Google Scholar] [CrossRef]
- Lin, X.; Xia, Y.; Yang, Y.; Wang, G.; Zhou, W.; Ai, L. Probiotic characteristics of Lactobacillus plantarum AR113 and its molecular mechanism of antioxidant. LWT. 2020, 126, 109278. [Google Scholar] [CrossRef]
- Los, F.C.; Randis, T.M.; Aroian, R.V.; Ratner, A. Role of pore-forming toxins in bacterial pathogenesis. Microbiol. Mol. Biol. Rev. 2013, 77, 173–207. [Google Scholar] [CrossRef]
- Egeblad, M.; Werb, Z. New functions for the matrix metalloproteinases in cancer progression. Nat. Rev. Cancer 2002, 2, 161–174. [Google Scholar] [CrossRef]
- Kessenbrock, K.; Plaks, V.; Werb, Z. Matrix metalloproteinases: Regulators of the tumor microenvironment. Cell 2010, 141, 52–67. [Google Scholar] [CrossRef]
- Food and Agriculture Organization; World Health Organization. Guidelines for the Evaluation of Probiotics in Food; FAO/WHO: Rome, Italy, 2002. [Google Scholar]
- Zolotukhin, P.V.; Prazdnova, E.V.; Chistyakov, V.A. Methods to Assess the Antioxidative Properties of Probiotics. Probiotics Antimicrob. Proteins 2018, 10, 589–599. [Google Scholar] [CrossRef] [PubMed]
- Lu, W.; Wang, Y.; Fang, Z.; Wang, H.; Zhu, J.; Zhai, Q.; Zhao, J.; Zhang, H.; Chen, W. Bifidobacterium longum CCFM752 prevented hypertension and aortic lesion, improved antioxidative ability, and regulated the gut microbiome in spontaneously hypertensive rats. Food Funct. 2022, 13, 6373–6386. [Google Scholar] [CrossRef]
- Dev, K.; Mir, N.A.; Biswas, A.; Kannoujia, J.; Begum, J.; Kant, R. Dietary Mannan-oligosaccharides potentiate the beneficial effects of Bifidobacterium bifidum in broiler chicken. Lett. Appl. Microbiol. 2020, 71, 520–530. [Google Scholar] [CrossRef] [PubMed]
- Wu, Q.; Qu, H.; Jia, J.; Kuang, C.; Wen, Y.; Yan, H.; Gui, Z. Characterization, antioxidant and antitumor activities of polysaccharides from purple sweet potato. Carbohydr. Polym. 2015, 132, 31–40. [Google Scholar] [CrossRef] [PubMed]
- Fu, X.; Xie, M.; Lu, M.; Shi, L.; Shi, T.; Yu, M. Characterization of the physicochemical properties, antioxidant activity, and antiproliferative activity of natural melanin from S. reiliana. Sci. Rep. 2022, 12, 2110. [Google Scholar] [CrossRef] [PubMed]
- Khemakhem, I.; Abdelhedi, O.; Trigui, I.; Ayadi, M.A.; Bouaziz, M. Structural, antioxidant and antibacterial activities of polysaccharides extracted from olive leaves. Int. J. Biol. Macromol. 2018, 106, 425–432. [Google Scholar] [CrossRef] [PubMed]
- Averina, O.V.; Poluektova, E.U.; Marsova, M.V.; Danilenko, V.N. Biomarkers and utility of the antioxidant potential of probiotic Lactobacilli and Bifidobacteria as representatives of the human gut microbiota. Biomedicines 2021, 9, 1340. [Google Scholar] [CrossRef]
- Zhang, J.; Wang, S.; Zeng, Z.; Qin, Y.; Shen, Q.; Li, P. Anti-diabetic effects of Bifidobacterium animalis 01 through improving hepatic insulin sensitivity in type 2 diabetic rat model. J. Funct. Foods 2020, 67, 103843. [Google Scholar] [CrossRef]
- Wang, Y.; Wu, Y.P.; Wang, Y.Y.; Xu, H.; Mei, X.Q.; Yu, D.Y.; Wang, Y.B.; Li, W.F. Antioxidant Properties of Probiotic Bacteria. Nutrients 2017, 9, 521. [Google Scholar] [CrossRef]

| Test Sample | Zone Diameter (mm) | ||
|---|---|---|---|
| Escherichia coli | Staphylococcus aureus | Staphylococcus epidermidis | |
| Untreated control | 12.94 ± 0.18 a | 14.81 ± 0.22 a | 17.62 ± 0.17 a |
| Catalase | 12.74 ± 0.28 a | 14.75 ± 0.21 a | 17.67 ± 0.19 a |
| Trypsin | 10.38 ± 0.23 b | 10.37 ± 0.15 b | 13.41 ± 0.07 b |
| Proteinase K | — | — | — |
| Alkaline protease | 7.32 ± 0.21 c | 8.49 ± 0.31 c | 6.34 ± 0.19 c |
| Papain | 6.64 ± 0.17 d | 8.06 ± 0.13 d | 5.87 ± 0.30 d |
| Pepsin | — | — | — |
Disclaimer/Publisher’s Note: The statements, opinions and data contained in all publications are solely those of the individual author(s) and contributor(s) and not of MDPI and/or the editor(s). MDPI and/or the editor(s) disclaim responsibility for any injury to people or property resulting from any ideas, methods, instructions or products referred to in the content. |
© 2025 by the authors. Licensee MDPI, Basel, Switzerland. This article is an open access article distributed under the terms and conditions of the Creative Commons Attribution (CC BY) license (https://creativecommons.org/licenses/by/4.0/).
Share and Cite
Ji, J.; Li, T.; Ma, B.; Wang, R. A Bifidobacterium Strain with Antibacterial Activity, Its Antibacterial Characteristics and In Vitro Probiotics Studies. Microorganisms 2025, 13, 1190. https://doi.org/10.3390/microorganisms13061190
Ji J, Li T, Ma B, Wang R. A Bifidobacterium Strain with Antibacterial Activity, Its Antibacterial Characteristics and In Vitro Probiotics Studies. Microorganisms. 2025; 13(6):1190. https://doi.org/10.3390/microorganisms13061190
Chicago/Turabian StyleJi, Jing, Tiange Li, Baoying Ma, and Runzhong Wang. 2025. "A Bifidobacterium Strain with Antibacterial Activity, Its Antibacterial Characteristics and In Vitro Probiotics Studies" Microorganisms 13, no. 6: 1190. https://doi.org/10.3390/microorganisms13061190
APA StyleJi, J., Li, T., Ma, B., & Wang, R. (2025). A Bifidobacterium Strain with Antibacterial Activity, Its Antibacterial Characteristics and In Vitro Probiotics Studies. Microorganisms, 13(6), 1190. https://doi.org/10.3390/microorganisms13061190

